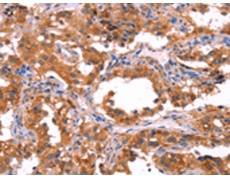
一抗

|
Background: |
This gene encodes a constitutively active member of the small GTPase Ras protein family. The encoded protein activates the phosphatidylinositol 3-kinase signal transduction pathway in undifferentiated stem cells, but is not expressed in differentiated cells. This gene may be involved in cancer and chemotherapy resistance. |
|
Applications: |
ELISA, WB, IHC |
|
Name of antibody: |
ERAS |
|
Immunogen: |
Synthetic peptide of human ERAS |
|
Full name: |
ES cell expressed Ras |
|
Synonyms: |
HRAS2; HRASP |
|
SwissProt: |
Q7Z444 |
|
ELISA Recommended dilution: |
2000-5000 |
|
IHC positive control: |
Human thyroid cancer and Human ovarian cancer |
|
IHC Recommend dilution: |
50-200 |
|
WB Predicted band size: |
25 kDa |
|
WB Positive control: |
Mouse heart tissue |
|
WB Recommended dilution: |
500-2000 |


 購物車
購物車 幫助
幫助
 021-54845833/15800441009
021-54845833/15800441009